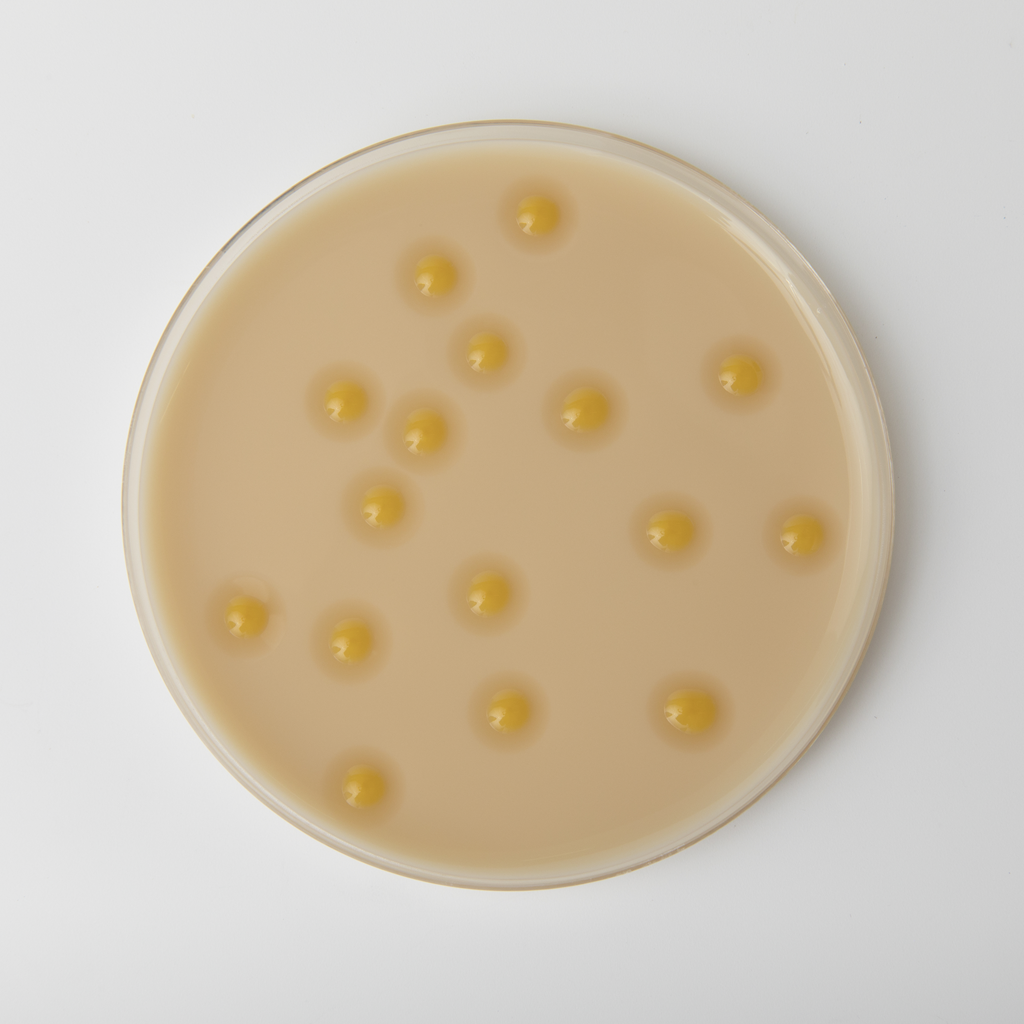
Screening a petri dish

Formulation of microbial biopesticides
Microbes can be beneficial throughout agriculture. Probably the most well-known are biopesticides, which can control insects (bioinsecticides) or pathogens (biofungicides). Other important groups are biofertilisers, which form symbiotic relationships with plants to provide nutrients to the plant and biostimulants which enhance nutrition efficiency, abiotic stress tolerance and crop quality. Other microbes can have a major impact on the environment, such as nitrogen fixators and carbon sequesters which can help in the reduction of greenhouse gasses.
However, microbes on their own would not be effective in agriculture as viability would be lost before they could reach their intended target, whether that is the soil or on a leaf. Formulation of microbial biopesticides is about providing a suitable delivery system that maintains the viability of the microbe until it is delivered to its end application.
Here you can gain advice on how to formulate microbial biopesticides (or biocontrol products), including what you need to consider prior to formulating and product recommendations.
How to formulate microbial biopesticides
Formulation of microbes as biopesticides can present a range of challenges from end product stability to maintaining viability of the microbe. Before starting formulation development there are initial factors that needs to be considered including:
- What shelf life is required?
- Do you want the final formulation to be liquid or solid?
- What is the intended target (soil or foliar)?
- How is it going to be applied (seed treatment or sprayed)?
- Does the microbe need protecting from any external factors (e.g. UV light)?
Answering these questions will help design the ideal formulation for your specific microbe and intended application.
Selecting the formulation delivery system
It is essential to select the right delivery system according to the microbe so understanding the microbe is key to formulation success. The morphological structure of the microbe can be extremely hydrophobic making their dilution in water ineffective and unevenly dispersed, resulting in problematic field application. Also, the presence of water can encourage dormant spores to begin to grow therefore reducing the viability of the active substance at the time of spraying.
Water free systems can provide an almost inert environment for the microbe during storage. Therefore, when formulating with microbials, oil dispersions (OD) or wettable powders (WP) are the most suitable formulation type.
OD microbial formulations
Key considerations when formulating as an OD:
- The chosen oil must not impact the viability of the microbe
- Formulation aids must be water free or have very low moisture content to ensure microbe viability is not impacted
- Dispersant should anchor to the substrate effectively without disrupting the organism
- Processing method of the formulation should be considered
- Emulsifier and rheology modifier are oil dependent - use Croda's OD chassis where surfactants and rheology modifier ratios have already been identified for specific oils
Developing microbial oil dispersion (OD) formulations

Making OD development more efficient
To facilitate the development process, we have designed four emulsion chassis systems for microbial delivery in a range of oils, selected to capture the unique requirements of different microbes. These chassis are an excellent starting point for developments with microbes, which allow further optimisation after initial compatibility testing has been completed.
The main benefit of these OD chassis recipes is that they significantly decrease the formulation development time and can be used even with limited formulation experience. This is because:
- There is confidence in initial compatibility with common microbes
- Surfactant choice and ratios have already been identified for each oil
- The formulation method is provided with best practice advice
WP microbial formulations
WPs are powder formulations that form a suspension when mixed with water prior to spraying. As they are in solid form, they are simple to produce and there are no storage sedimentation issues. The water free environment reduces spore germination issues during storage and no preserving agent is required which is beneficial as these can often be harmful to the microbe you are trying to formulate. As a powder formulation there are limitations such as the potential inhalation hazard and end user handling.
Key considerations when formulating as a WP:
- Surfactants should overcome the highly hydrophobicity of the microbe for better wetting and suspensibility
- Formulation aids should be in solid form

Microbial seed treatment
Throughout development initial compatibility testing is recommended to understand whether individual components or full formulations are compatible with a microbe. There are several methods to assess how the formulation is impacting the microorganism survival. Here are a few examples of industry standard methods that we use.
- Zone of Inhibition (Kirby - Bauer test) assesses compatibility of microbes with various formulation aids or full formulations
- Colony forming units (CFU) determination - evaluates the colonisation capacity (or strength) of the microbe when it is applied on the substrate in the presence of formulation aids.
- Conidia germination test (CGT direct viability) is mainly used for evaluation of the germination capacity of fungal conidia and how chemical components like raw materials, inerts, agrochemicals, etc. can effect the survival of fungi.
- Conidia vigor measurement, the newest method developed in our lab, is the speed at which a microbe germinates. Some products can specifically affect the conidia vigor, affecting the fungi performance when applied in the field. Our PrecisionBio™ software measures conidia vigor over time through imagery on an optical microscope. It is possible to analyse how each formulation (or component itself) can affect individually the conidia vigor over time. Therefore, this method generates more in-depth understanding of how formulation components can affect a microbe.
Here is an example of using the zone of inhibition method to test initial compatibility of some of Croda's products with Bacillus sp., Trichoderma sp. and Pseudomonas sp.
Product recommendations
Understanding and knowing your specific microbe is important. Some useful points to note are:
- Same species but different strains can report different compatibility with formulation aids
- The same strain can report different performance when it is under different environmental conditions
- Depending on the target, one strain may perform better than another
- Each strain has its own peculiarities
Therefore, making general product recommendations is difficult. As a starting point for OD developments, download the Formulating microbial OD chassis datasheet for product recommendations. However, we highly encourage you to get in touch so we can work together to provide more tailored advice to your specific microbe.